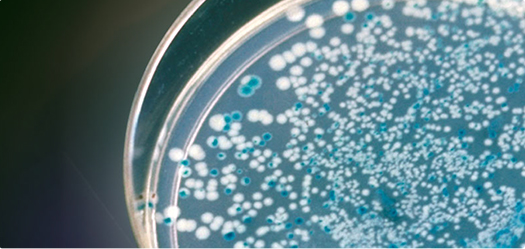

TOP Gene Technologies subcloning services generate any plasmid constructs you want. Project will be quoted according to the most cost-effective strategic plan chosen for you by our professionals. We provide timely
project update.
Project quote is based on insert length, restriction enzymes chosen and type of vector. Please contact info@topgenetech.com for quotation. Customers need to provide us with insert DNA sequence, name of vectors, and sequencing chromatograms. If sequencing data are not available we may sequence the plasmid before subcloning and the customer will be responsible for any sequencing cost.
TOP Gene Technologies provides large scale plasmid preparation services (Maxi-prep and endo-free Maxi-prep).
Our high quality ensure Plasmid highly efficient cell transfection, DNA vaccination and antibody production.